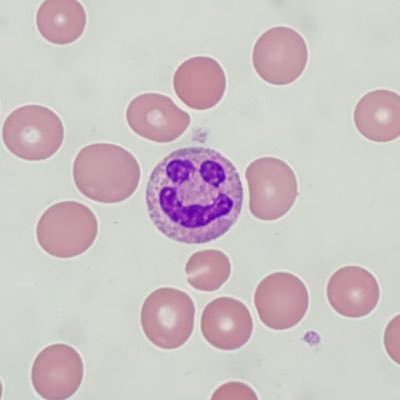
VariantLymph's profile picture. chief of pathology at Outside Community Hospital Medical Center. glass pusher. cell counter. has never gotten oil on the 40x.

Editing TheGrayLady
@nyt_diff
🤖 highlighting changes to news on main page of @nytimes. By @j_e_d. Based on 💡 of @newsdiffs. 🔝 edits: https://twitter.com/search?q=(from%3Anyt_diff)%20min_faves%3A500&src=typed_query&f=live
Beigetreten im August 2016
Was dir gefallen könnte
Angepinnt
0
1
6
2
19Tsd.
United States Trends
- 1. Good Thursday 28.9K posts
- 2. #WeekndTourLeaks N/A
- 3. #thursdaymotivation 1,767 posts
- 4. Happy Friday Eve N/A
- 5. #ThursdayThoughts 1,720 posts
- 6. #thursdayvibes 2,423 posts
- 7. FEMA 83K posts
- 8. Nnamdi Kanu 69.8K posts
- 9. #หลิงออมปฏิทินช่อง3ปี2569 805K posts
- 10. LINGORM CH3 CALENDAR SIGN 796K posts
- 11. Crockett 61.9K posts
- 12. The 2024 90.4K posts
- 13. NO CAP 15K posts
- 14. The 1990 7,771 posts
- 15. FREE HAT 1,973 posts
- 16. But Jesus 22.4K posts
- 17. Alignerz 216K posts
- 18. Shamet 3,250 posts
- 19. Lee Zeldin 14.1K posts
- 20. Hire American 5,661 posts
Was dir gefallen könnte
-
 ProPublica
ProPublica
@propublica -
 Dave Wasserman
Dave Wasserman
@Redistrict -
 Liz Franczak
Liz Franczak
@liz_franczak -
 Boots Riley
Boots Riley
@BootsRiley -
 Ken Klippenstein (NSPM-7 Compliant)
Ken Klippenstein (NSPM-7 Compliant)
@kenklippenstein -
 Taylor Lorenz
Taylor Lorenz
@TaylorLorenz -
 Greg Sargent
Greg Sargent
@GregTSargent -
 Current Affairs
Current Affairs
@curaffairs -
 Ashley Feinberg (ashleyfeinberg.bsky.social)
Ashley Feinberg (ashleyfeinberg.bsky.social)
@ashleyfeinberg -
 Jason Leopold
Jason Leopold
@JasonLeopold -
 Julia Salazar (@juliasalazar on bluesky)
Julia Salazar (@juliasalazar on bluesky)
@JuliaCarmel__ -
 Olivia Nuzzi
Olivia Nuzzi
@Olivianuzzi -
 David Dayen
David Dayen
@ddayen -
 Ryan Lizza
Ryan Lizza
@RyanLizza -
 Jeet Heer
Jeet Heer
@HeerJeet
Loading...
Something went wrong.
Something went wrong.